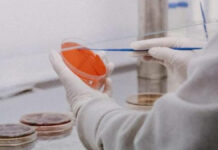
Descifran secuencia completa del virus de la viruela del mono Un grupo de investigadores del Instituto de Salud Carlos III (ISCIII) elaboraron el primer borrador de la secuencia.

Argentina confirma primer caso de viruela del mono
El Ministerio de Salud de Argentina confirmó su primer caso de viruela de mono, sería el primer caso en América Latina.
Autora de “Cómo asesinar a tu marido” condenada por asesinar a su marido
Nancy Crampton Brophy, de 71 años, autora del ensayo de "Como asesinar a tu marido" fue condenada por asesinar a su marido.
Gobierno ofrece protección a víctima de ataque con ácido
Tras darse a conocer el supuesto ataque, personal de la administración estatal se puso en contacto con la hija de la mujer.
“Era un chico tranquilo”: familiares de Salvador Ramos
La madre de Salvador Ramos, el autor del tiroteo en Uvalde, expresó su pésame a las familias de las victimas por los actos de su hijo.
Sujeto robó cuotas escolares y abrió un bar, acusan padres
El presidente del Comité habría robado cerca de 300 mil pesos de cuotas escolares, dinero que al parecer usó para abrir un bar.
Entregan financiamiento número 100 a emprendedora
A sólo un mes de que incidió el programa de Créditos Contigo ya se recibieron más de 900 solicitudes de financiamiento.
Encuentran 30 delfines muertos en las costas de BCS
Un total de 30 delfines fueron encontrados muertos en las Costas de Baja California Sur, provenientes del Mar de Cortés.
Destruyen 4 toneladas de cerveza y bebidas alcohólicas en CDMX
Las 4 toneladas de bebidas alcohólicas fueron entregadas de forma voluntaria por los dueños de los negocios.
Texas: niña fingió muerte y así sobrevivió a tiroteo
La niña de 11 años se llenó de sangre para no ser atacada en el tiroteo de Texas, según contó su tía para Click 2 Houston.
Texas: Gobernador cancela reunión con Asociación del Rifle
El gobernador de Texas, Greg Abbott, no asistirá a la reunión anual de la Asociación Nacional del Rifle luego del tiroteo en Uvalde.
Secuestro de abuelito deja sentencia de 95 años para tres
Las tres personas recibieron sentencia, multa y deberán pagar reparación del daño por el secuestro de un adulto mayor.
Iglesia italiana prepara informe sobre abusos a menores
Aunque víctimas pidieron un informe sobre abusos sexuales en los últimos 60-70 años, la iglesia de Italia abarcará sólo 20 años.
Descifran secuencia completa del virus de la viruela del mono
Un grupo de investigadores del Instituto de Salud Carlos III (ISCIII) elaboraron el primer borrador de la secuencia.
Venezuela y Nicaragua, fuera de la Cumbre de las Américas
Estados unidos confirmó este jueves 26 de mayo, que Venezuela y Nicaragua no fueron invitados a la Cumbre de las Américas.
Estas 3 películas ganaron la Cinef del Festival de Cine de Cannes
La Cinef selecciona entre 15 y 20 cortometrajes o películas de mediana duración provenientes de escuelas de cine de alrededor del mundo.
Guardia Nacional ubica toma clandestina en Puebla
La Guardia Nacional notificó los hallazgos a la autoridad ministerial para continuar con las investigaciones correspondientes.
Esposo de maestra asesinada en tiroteo muere de un infarto
"Vengo con un profundo dolor para decir que el esposo de mi tía Irma, Joe García, falleció debido al dolor", comentó el sobrino de la pareja.
SEP Puebla actualiza y capacita a profesores
El encuentro organizado por la SEP fue identificar la problemática actual académica y social para mejorar la formación docente.
Hallan cadáver en los límites de Yehualtepec y Tecamachalco
Entre los límites de los municipios de Yehualtepec y Tecamachalco, fue localizado el cuerpo sin vida de un hombre este jueves.
Se trata del cuerpo...
Pachuca-Atlas: ¡Hasta 100 mil pesos un palco!
A poco más de 72 horas de la final de vuelta entre Pachuca y Atlas, hasta cerca de 100 mil pesos están alcanzando los...